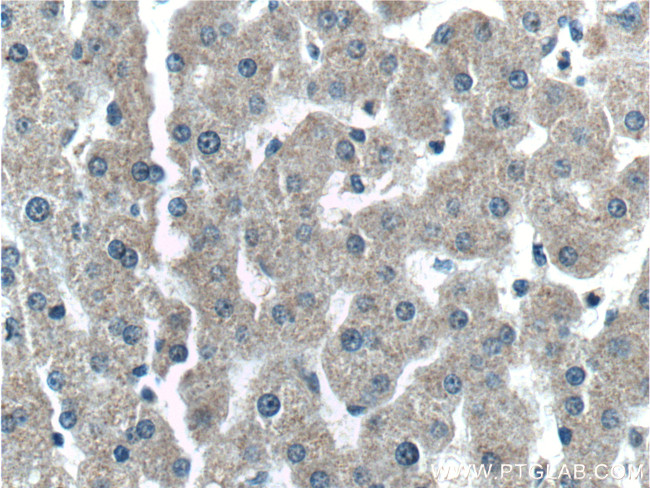
C4 gamma chain Antibody in Immunohistochemistry (Paraffin) (IHC (P))

Search
Proteintech
C4 gamma chain Monoclonal Antibody (2G6A7)
{{$productOrderCtrl.translations['antibody.pdp.commerceCard.promotion.promotions']}}
{{$productOrderCtrl.translations['antibody.pdp.commerceCard.promotion.viewpromo']}}
{{$productOrderCtrl.translations['antibody.pdp.commerceCard.promotion.promocode']}}: {{promo.promoCode}} {{promo.promoTitle}} {{promo.promoDescription}}. {{$productOrderCtrl.translations['antibody.pdp.commerceCard.promotion.learnmore']}}
产品信息
66242-1-IG
种属反应
宿主/亚型
分类
类型
克隆号
抗原
偶联物
形式
浓度
规格
纯化类型
保存液
内含物
保存条件
运输条件
产品详细信息
This antibody raised against 1543-1744aa of human C4-A protein recognizes C4 gamma chain.
Immunogen sequence: EVPVGLVQP ASATLYDYYN PERRCSVFYG APSKSRLLAT LCSAEVCQCA EGKCPRQRRA LERGLQDEDG YRMKFACYYP RVEYGFQVKV LREGSRAAFR LFETKITQVL HFTKDVKAAA NQMRNFLVRA SCRLRLEPGK EYLIMGLDGA TYDLEGHPQY LLESNSWIEE MPSERLCRST RQRAACAQLN DFLQEYGTQG CQV (1-202 aa encoded by BC012372)
靶标信息
This gene encodes the acidic form of complement factor 4, part of the classical activation pathway. The protein is expressed as a single chain precursor which is proteolytically cleaved into a trimer of alpha, beta, and gamma chains prior to secretion. The trimer provides a surface for interaction between the antigen-antibody complex and other complement components. The alpha chain may be cleaved to release C4 anaphylatoxin, a mediator of local inflammation. Deficiency of this protein is associated with systemic lupus erythematosus and type I diabetes mellitus. This gene localizes to the major histocompatibility complex (MHC) class III region on chromosome 6. Varying haplotypes of this gene cluster exist, such that individuals may have 1, 2, or 3 copies of this gene.
仅用于科研。不用于诊断过程。未经明确授权不得转售。
篇参考文献 (0)
生物信息学
蛋白别名: acidic C4; Acidic complement C4; C3 and PZP-like alpha-2-macroglobulin domain-containing protein 2; c4 complement; c4 propeptide; C4A anaphylatoxin; Complement C4-A; complement C4A (Rodgers blood group); complement component 4A (Rodgers blood group); MHC class III region complement; Rodgers form of C4; unnamed protein product; ZA
基因别名: C4; C4A; C4A2; C4A3; C4A4; C4A6; C4AD; C4S; CO4; CPAMD2; RG
UniProt ID: (Human) P0C0L4
Entrez Gene ID: (Human) 720